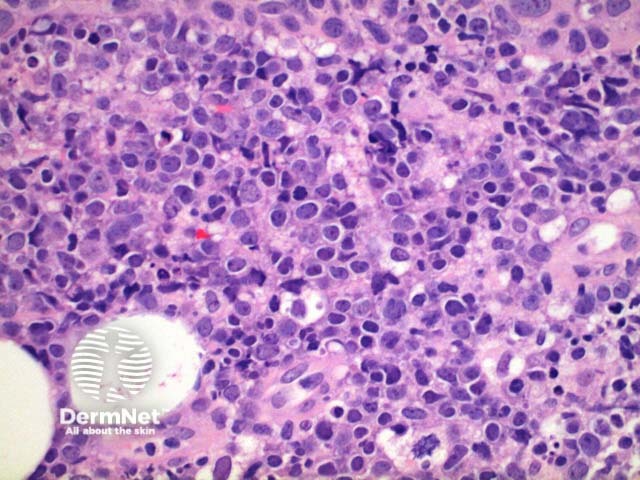
Figure 7

Main menu
Common skin conditions
NEWS
Join DermNet PRO
Read more
Quick links
Lesions (cancerous) Diagnosis and testing
Author: Dr Ben Tallon, Dermatologist/Dermatopathologist, Tauranga, New Zealand, 2010.
Introduction Histology Special stains Differential diagnoses
Within the group of cutaneous B cell lymphomas, further categorisation includes primary cutaneous diffuse large B cell lymphoma, leg type; primary cutaneous diffuse large B cell lymphoma, other; plasmablastic lymphoma and T cell-rich large B cell lymphoma. The primary cutaneous B cell lymphoma leg type indicates a poor prognostic group typically seen on the lower legs of the elderly and is illustrated in the figures below.
Scanning power view of the histology of primary cutaneous diffuse large B cell lymphoma is of a dense superficial and deep cellular infiltrate (figure 1). Higher power identifies a dense atypical lymphocytic proliferation, which frequently extends into the subcutaneous tissue (figures 2, 3, 4, 5). Areas of crush artefact are common, and while not specific may be a clue to a malignant lymphoid population (figures 2, 3). The lymphocytes are large centroblast-like and immunoblast-like cells with non-cleaved nuclei and prominent nucleoli (figure 6, 7).

Figure 1

Figure 2

Figure 3

Figure 4

Figure 5

Figure 6
Figure 7
Immunostaining reveals a CD20 positive B (figure 8) cell population with diffuse BCL2 (figure 9) and MUM1 staining. BCL6 expression is variable while CD10 is negative.

Figure 8

Figure 9
Primary cutaneous diffuse large B cell lymphoma, other, refers to those cases where the clinical features, histology and immunohistochemistry do not fit with primary cutaneous diffuse large B cell lymphoma, leg type, while also not consistent with a diagnosis of primary cutaneous follicle centre lymphoma.